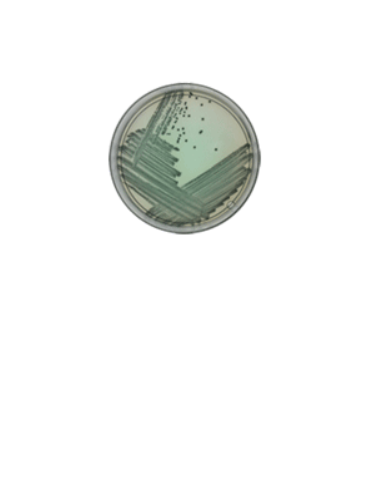
Rainbow Agar O157
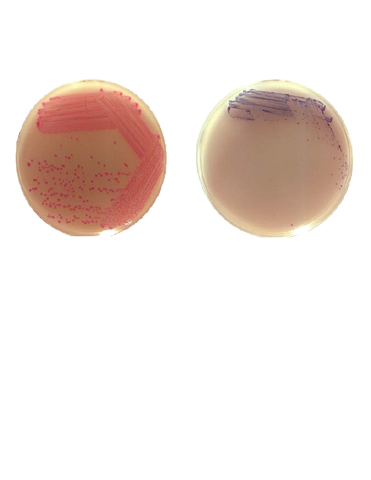
Rainbow Agar Shigella/Aeromonas

Microbial Detection using Chromogenic Media
Rainbow® Agars offer a simple selective and chromogenic medium to help you conveniently detect strains of E. coli O157, Salmonella, Shigella and Aeromonas with results in less than 24 hours